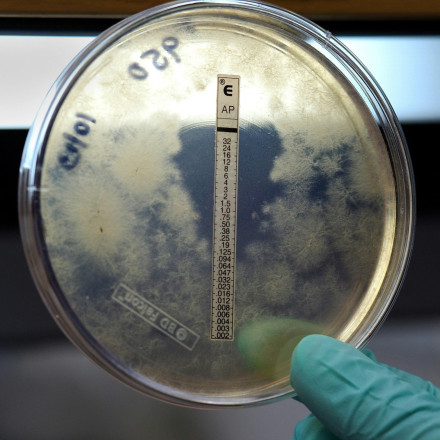
Βγήκε από τη ΜΕΘ η γιατρός που είχε προσβληθεί από μηνιγγίτιδα - «Ξεπέρασε τον κίνδυνο»

Συναγερμός στον Βόλο: 30χρονη μητέρα νοσηλεύεται με μηνιγγίτιδα - Γέννησε πριν από 20 ημέρες
Το μωρό θα υποβληθεί σε εξετάσεις όπως και όλο το οικογενειακό περιβάλλον και όσοι ήρθαν σε επαφή με την νεαρή γυναίκα.


Τα τελευταία νέα και ότι πρέπει να γνωρίζεις για τη μηνιγγίτιδα
Το μωρό θα υποβληθεί σε εξετάσεις όπως και όλο το οικογενειακό περιβάλλον και όσοι ήρθαν σε επαφή με την νεαρή γυναίκα.

Στους Πανελλήνιους Αγώνες Special Olympics «Λουτράκι 2026» συμμετείχαν περισσότεροι από 450 αθλητές.
Σε σοβαρή αλλά σταθερή κατάσταση νοσηλεύεται διασωληνωμένος στο Πανεπιστημιακό Γενικό Νοσοκομείο Πατρών στο Ρίο μαθητής ειδικού σχολείου.

Ποια είναι τα συμπτώματα και πως μεταδίδεται η πολύ σοβαρή λοίμωξη που προσβάλει τον εγκέφαλο και τον νωτιαίο μυελό.

Οι υγειονομικές υπηρεσίες έχουν ενημερωθεί ήδη και ξεκίνησαν ιχνηλάτηση των επαφών της αν και φαίνεται πως δεν υπάρχει κίνδυνος για διασπορά.

Όπως αναφέρει ο πρόεδρος της ΠΟΕΔΗΝ, Μιχάλης Γιαννάκος, ο νεαρός αποσωληνώθηκε κι έχει επικοινωνία, ενώ συνεχίζει να νοσηλεύεται στη ΜΕΘ του νοσοκομείου Τρικάλων.

Όπως αναφέρεται, ο ασθενής παραμένει διασωληνωμένος στη Μονάδα Εντατικής Θεραπείας σε σταθερή και σταδιακά βελτιούμενη κατάσταση.

Τα πρώτα συμπτώματα μηνιγγίτιδας του 19χρονου φοιτητή του ΑΠΘ εμφανίστηκαν το Σαββατοκύριακο.

Σε εξέλιξη βρίσκεται ιχνηλάτηση των επαφών του νεαρού φοιτητή ο οποίος είχε παρακολουθήσει κανονικά τα μαθήματά του την περασμένη εβδομάδα.

Οι υγειονομικές Αρχές του Ηνωμένου Βασιλείου εξέδωσαν προειδοποίηση προς τους γιατρούς στην Αγγλία να προσέχουν για συμπτώματα μηνιγγίτιδας.

Η Γαλλία επιβεβαίωσε το πρώτο κρούσμα μηνιγγίτιδας. Πρόκειται για έναν φοιτητή που βρισκόταν στο Πανεπιστήμιο Κεντ τις προηγούμενες ημέρες.

Χιλιάδες φοιτητές αλλά και μαθητές σπεύδουν να λάβουν προληπτικά αντιβιοτικά με τις Αρχές να είναι σε αυξημένη επαγρύπνηση.

Η νεαρότερη αδερφή δείχνει να παρουσιάζει σημάδια βελτίωσης, ενώ πιο κρίσιμη παραμένει η κατάσταση της 26χρονης στη ΜΕΘ Χανίων.

Η συγκινητική ανάρτηση που έκανε ο διευθυντής της ΜΕΘ Παίδων του Πανεπιστημιακού Νοσοκομείου της Πάτρας, Ανδρέας Ηλιάδης.

Η καταγγελία μητέρας για τη συγκεκριμένη γιατρό αφορά περιστατικό από το 2022.

«Δεν θα μου πεις εσύ πότε θα έρθω», φαίνεται να είπε στους γονείς του παιδιού όταν την ρώτησαν γιατί δεν ήταν εκεί.

Αισιόδοξη φαίνεται να είναι πλέον η κατάσταση της υγείας του μωρού.

Στο νοσοκομείο του Ρίου το βρέφος διαγνώστηκε με βακτηριακή μηνιγγίτιδα και επιθετική μηνιγγιτιδοκοκκική σηψαιμία. Καταγγέλλουν την παιδίατρο για αμέλεια.

Η παιδίατρος εξηγεί τον λόγο που δεν μπορούσε να παραστεί στο νοσοκομείο Ζακύνθου.

Ο υπουργός Υγείας γνωστοποίησε πως έχει διαταχθεί ΕΔΕ για την παιδίατρο στη Ζάκυνθο. Ανακοίνωση εξέδωσε το νοσοκομείο.
